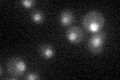
YJL110C
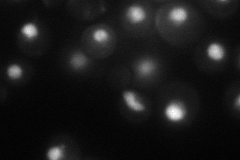
YJL110C
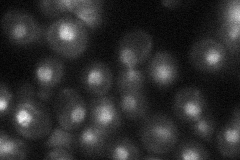
YJL110C
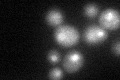
YJL110C

View description
GATA zinc finger protein and Dal80p homolog that negatively regulates nitrogen catabolic gene expression by competing with Gat1p for GATA site binding; function requires a repressive carbon source; dimerizes with Dal80p and binds to Tor1p
Localization:
Intensity:
Fold change:
Significance:
-
C’ GFP library in SD
nucleus26.44 -
N' NOP1pr-GFP in SD
nucleus,nucleolus59.134 -
N' TEF2pr-mCherry in SD

nucleus,nucleolus6.55261 -
N' NATIVEpr-GFP in SD
nucleus29.7618 -
N' TEF2pr-VC and Cyto-VN in SD

punctate,nucleus33.6733 -
C’ GFP library in SD+DTT
nucleus22.630.85No -
C’ GFP library in SD+H2O2

nucleus24.920.94No -
C’ GFP library in Starvation Media

nucleus16.160.61Yes -
C’ GFP library on the background of Pup2-DaMP

nucleus -
C’ GFP library on the background of CCT mutant

nucleus27.83061.05219No
